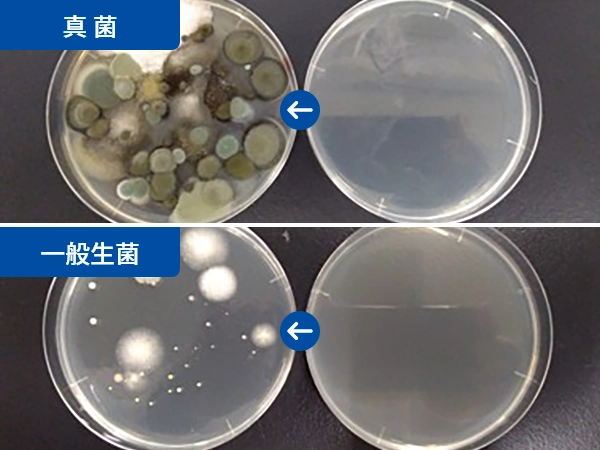
浮遊真菌調査・落下菌検査

カビ除去
根源から断つ、圧倒的な除菌技術
見えない胞子まで徹底的に封じ込める
THOUGHTS清潔な空気が、一番のインテリアです
一般的なカビ取り剤は「カビ取り=拭き掃除+漂白剤」が主流です。
クリーンメイトのカビ取りは
「胞子レベルまで除去+即効性」に優れています。
クリーンメイトで使用しているカビ除去システムは、オーストラリアで開発された、プロフェッショナル専用のカビ修復システム「GOLDMORR(ゴールドモア)」になります。
このシステムは、世界20カ国以上で採用されている国際基準のモールドリメディエーション技術で、壁や天井などに発生した「見えるカビ」だけでなく、空気中に漂う「見えないカビ胞子」まで根本から除去します。
使用する専用材破無漂白・無刺激・非腐食性・生分解性の安全設計で素材や建物を傷めることなく、室内環境を清浄化できるのが大きな特徴です。(GM2000のみ)
クリーンメイトでは、GOLDMORR認定テクニシャンによる正しい施工と温度管理のアドバイスにより、カビの再発を長期間にわたって防止し、安心して過ごせる空間を取り戻します。
クリーンメイトでは、この国際技術を日本の住宅環境に最適化し、水害・漏水・結露・生活臭など複合的なトラブルにも対応できる態勢を整えています。
TECHNICクリーンメイトの技術(※すべてオプションになります)

- 臭気・揮発性有機化合物(VOC)測定
- GC-MS/MSによる室内環境臭気分析を行い、カビ特有の臭いや化学物質を正確に検出します。空気中の揮発成分を数値化することで、汚染の程度や健康リスクを客観的に評価し、安全で快適な空間づくりに役立てます。
- 浮遊真菌調査・落下菌検査
- 浮遊真菌調査・落下菌検査は、微生物のモニタリングに有効な検査方法です。培地検査結果後、室内のカビ対策に住環境設備、異なった清掃方法の改善に役立てることが可能になります。

- 表面カビ菌採取検査
- 壁や床、天井などの表面からサンプルを採取し、カビの繁殖部位や種類を科学的に特定します。発生原因を明確にすることで、再発を防ぐための対策を立てやすくなり、より効果的な施工につなげることができます。

- 気中パーティクル検査
- 室内の空気中に浮遊するカビ胞子や微粒子を専用の測定機器で測定し、汚染の度合いを数値化します。目に見えないカビや微粒子の概算数を可視化することで、実際の空気環境を正確に把握し、最適な除菌・防カビ施工につなげます。

- 温度・湿度測定
- 室内外の温度や湿度、露点温度などを詳細に測定し、カビが発生しやすい環境要因を調べます。データをもとに、発生リスクを減らすための換気・除湿・施工方法を検討し、快適な住環境を維持します。

- 徹底乾燥
- 乾燥専用の高性能送風機を使用し、効率的かつ均一な乾燥を実現します。建材内部に残る湿気をしっかり除去することで、カビの再発リスクを大幅に抑え、長期的に清潔な環境を保つことができます。

- 洗浄前後ATP測定
- ATP測定器(A3法)を用いて作業前後の汚染度を数値で確認します。測定は約10秒で完了し、除菌の効果をその場で把握可能です。科学的根拠に基づく検査により、施工品質を高い精度で管理します。

- 含水率測定
- 壁や床下の木材、石膏ボードなどに残る水分量を専用センサーで精密に測定します。乾燥の進行度を確認しながら施工を進めることで、乾燥不足を防ぎ、再発しにくい状態を確実に整えます。

- 漏水調査
- カビが発生している個所では、隠蔽部にて漏水が発生しているケースもございます。ロガーを使った漏水調査により、クラウドでデータを監視し、狭い場所の漏水箇所を特定することが可能です。※状況によっては、必ずしも漏水箇所を特定できない場合があります。

- 防カビ剤 散布(GM2000)
- カビ除去後に専用防カビ剤「GM2000」を散布し、カビの再繁殖を長期間抑制します。素材や環境に合わせた安全な施工を行うことで、衛生的で快適な室内環境を維持することが可能です。

- 再発防止コーティング剤塗布
- カビ除去後に専用の防カビコーティング剤を塗布し、表面に保護膜を形成します。湿度や微粒子の影響を受けにくくなり、カビの定着を長期間防止します。清潔さを保つための仕上げ工程です。

- 高度除湿器レンタル
- 一般的な家庭用除湿器では取りきれない湿気を、業務用の高性能除湿器で徹底的に除去します。お部屋の広さや構造に合わせて最適な機種を選定し、施工後の乾燥と防カビ効果をより確実なものにします。
BEFORE & AFUTERビフォーアフター

5分後には
この状態
- CASE01
- 室内のカビ除去

5分後には
この状態
- CASE02
- 店舗天井のカビ除去
HOW TO USEカビ除去の流れ

カビ除去対策をされるお客様へご一読ください
- ・カビを除去しても、建物の状況・環境により再発する場合もございます。
- ・カビの再発は環境要因によるものが多く、施工保証の対象外になります。












